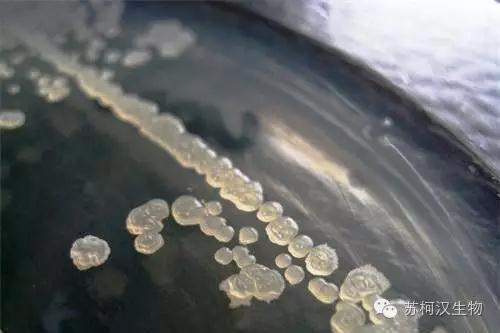

枯草芽孢杆菌是一种新型的微生物源生物农药。枯草芽孢杆菌在防治水稻、小麦、花生、番茄、辣椒、大豆、玉米等作物上的病害有较好的效果,特别是针对小麦白粉病、赤霉病、纹枯病等病害的防治效果更佳,田间增产率更是达到了10%~50%。

苏柯汉公司枯草芽孢杆菌具有更强的营养物质竞争能力以及氧气竞争优势;定殖、繁殖速度更快,迅速抑制其它病原微生物生存,起到“贴身”保护植物,确保植物健康成长的作用,所以国内专家对枯草芽孢杆菌的评价是“用量少,防效好,绿色又环保,增产又增收”。
1、绿色环保:对人畜无毒无害、不污染环境、对作物安全。
2、高效广谱:能产生多种抗菌素和酶,具有广谱抗菌活性和极强的抗逆能力。
3、增产提质:枯草芽孢杆菌还能够分泌促进作物生长的活性物质,使植株叶片浓绿肥厚,提高作物免疫力,增产提质效果显著,发酵过程中产生多种氨基酸,对作物有生长调节的作用。
1、提高作物抗病、抗寒、抗旱能力。
2、增加土壤养分、改良土壤结构、提高肥料利用率。
3、促使土壤中的有机质分解成腐殖质,刺激作物生长。
4、促进作物生长、成熟、降低成本、增加产量、提高收入。
5、有一定的固氮、解磷、解钾作用。
1.竞争作用:拌种或灌根后,枯草芽孢杆菌能够在作物种围、根表面、根内部以及通过植物导管传导到地上部分而在作物根表、根内、茎部、叶部等位点定殖和繁殖,保护作物根部不受病菌侵染和抑制作物体内病原菌扩散,从而达到防病作用。
2.杀菌作用:枯草芽孢杆菌在作物根表、根内、茎部、叶部等位点定殖和繁殖过程中,能产生脂肽类和蛋白类等杀菌物质,从而杀死作物病原菌,达到防病效果。
3.促生作用:枯草芽孢杆菌具有解磷作用,可以将土壤中无效磷转化为能被作物吸收的有效磷,促进作物根系及植株生长,提高了作物的抗病性。

1、稻瘟病、纹枯病、稻曲病。施药方法:水稻孕穗破口期和齐穗期各施药一次。每亩用枯草芽孢杆菌10克均匀喷雾,喷药药间隔7-12天。
2、枯草芽孢杆菌与咪鲜胺、三环唑、井冈霉素等混用,有明显的相互增效作用。在病害集中、急性暴发时,更能显示出混用的效果。
1、本品用量少,为减少浪费,兑药时应用小容器将所需用量药剂充分溶解后再倒入喷雾器中,加水至喷雾器最佳 水平线进行喷雾;
2、早上10点前或下午4点后施药,避免阳光直射,杀死芽孢。尤其是4点后用药,夜间潮湿的环境更有利于芽孢 萌发。
3、不能与铜制剂、链霉素等杀菌剂及碱性农药混用;
4、病害初期或发病前施药效果最佳,施药时注意使药 液均匀喷至作物各部位。